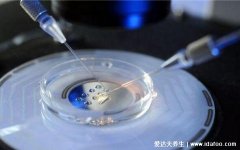
10个人做试管几个能成功，3-7人受很多因素影

试管婴儿可以做双胞胎吗,可以且几率比自然受孕高
想要去做试管婴儿,想要一对双胞胎,但是试管婴儿可以做双胞胎吗,其实是可以的,但是它的成功率可能没有异卵高,大家是需要做好心理准备的,但是它的几率比自然受孕高一些的。
试管婴儿可以做双胞胎吗,可以

在正常受孕的情况下,也不是说很容易就可以生双胞胎的,但是试管婴儿是可以做双胞胎的,但是需要注意,成功几率可能会比异卵的成功率小。而且在做试管婴儿的时候,是可以在母体内放2-3个胚胎的,是为了增加成功率,胚胎并不一定都是可以存活的,如果想要双胞胎的话,是需要2枚胚胎都是存活的。

但是大家也不要丧气,随着医疗水平的进步,双胞胎试管婴儿的概率是增加的,试管婴儿做双胞胎的成功率可以有24%,自然受孕的双胞胎是1.2%的。如果自己想要去做双胞胎的话,也还是需要做好可能失败的准备的,试管婴儿并不是一次就可以成功的,如果在怀有双胞胎之后,也是需要及时做检查的,需要格外注意的。

如果要去做试管婴儿的话,是需要经历一系列流程的,从全面检查、再到促卵、排卵等,女性都是会面临一些风险的,这可能会给女性的身体造成伤害,怀有双胞胎比异卵的风险要大,也是可能会让让女性出现强烈的妊娠反应的,可能易发生早产等。
试管婴儿可以做双胞胎吗,其实是可以的,而且几率可能比自然受孕要高一些,但是比异卵要低的,试管婴儿也会面临很多的风险的,大家可以6步看懂试管婴儿怎么做的全过程
6步看懂试管婴儿怎么做的全过程

在决定要做试管婴儿的时候,女性需要先进行促排卵治疗,不是每一个卵子都能受精的,要通过打针来促进排卵。医生会告诉大家需要注意的饮食事项,.......【查看详情】
本文由网上采集发布,不代表我们立场,转载联系作者并注明出处:http://www.qqmcw.cn/baike/2608.html